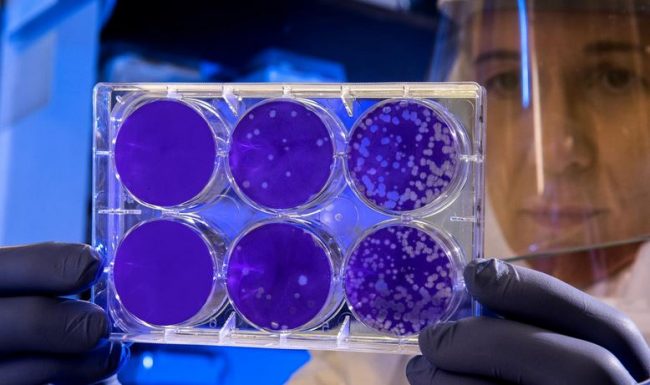

Dipendente positivo: sindaci, assessori
e due Comuni in quarantena
Un dipendente che lavora nel Comune di Ostra ma anche in quello di Ostra Vetere è risultato positivo al tampone: in via preventiva i sindaci e le giunte, oltre a gran parte del personale dei due enti locali, sono entrati in isolamento fiduciario. A ufficializzare la notizia sono state le stesse amministrazioni comunali di Ostra e Ostra Vetere con due distinti comunicati stampa dal contenuto univoco. «Il nostro Comune si è trovato ad affrontare ciò che nessuno di noi osava immaginare e che umanamente ci spaventa, come tutto ciò che non conosciamo e che mette a repentaglio le nostre sicurezze, le nostre abitudini e perfino la nostra vita. – esordisce stamattina il comunicato stampa del Comune di Ostra Vetere – Abbiamo vissuto ogni giornata in stretto contatto con le istituzioni sovraordinate e con gli altri Comuni, confrontandoci e collaborando con tutti coloro che, a vario titolo, stanno cercando con dedizione e impegno, credeteci, straordinari di frenare e contenere questa spietata epidemia. Purtroppo non siamo riusciti a impedire al virus di colpire uno dei nostri collaboratori più preziosi e presenti sul campo: un dipendente è risultato positivo al tampone del Coronavirus ed è attualmente ricoverato in ospedale».
La notizia è arrivata nella tarda serata di martedì e tutta la giornata di ieri è stata dedicata alla valutazione della posizione di colleghi del dipendente e amministratori, all’avvio dei vari protocolli e all’adozione di nuove misure di sicurezza. «In seguito ai colloqui avuti con i medici del Servizio Igiene e Sanità pubblica di Senigallia, il sindaco, gli assessori e la maggior parte del personale interno sono stati sottoposti ad isolamento fiduciario con sorveglianza attiva fino alla data del 20 marzo prossimo. – fa sapere la nota stanpa – Per tali motivi i servizi verranno assicurati attraverso la prenotazione ai numeri esposti nell’avviso affisso al portone del Comune e nel sito istituzionale nell’apposito link “coronavirus”».
Situazione analoga si era manifestata ieri anche nel Comune di Ostra dove il sindaco, la giunta e 11 dipendenti sono stati messi in quarantena con sorveglianza attiva fino alla data del 20 marzo. «Per garantire i servizi essenziali e poter rispondere alle emergenze è stato attivato il trasferimento di chiamata dei numeri comunali; per consentire ai dipendenti destinatari del provvedimento di svolgere a casa il proprio lavoro è stato istituito, con decreto del Sindaco, il “Lavoro Agile”, come auspicato dagli ultimi Decreti del Presidente del Consiglio dei Ministri, che consente ai dipendenti raggiunti dal provvedimento sanitario di poter svolgere da casa il proprio lavoro. Continueremo a lavorare quotidianamente in sinergia: le modalità nuove e inattese ci offriranno la possibilità di testare anche nuovi strumenti per affrontare le emergenze e le difficoltà» aveva spiegato in una nota l’amministrazione comunale di Ostra.
Articoli correlati
L’ospedale di Fabriano per le urgenze, aree dedicate al Covid negli altri presidi: ecco le misure varate dalla Regione
«Imprese produttive restano aperte ma va garantita la sicurezza: faremo controlli negli stabilimenti»
Italia blindata, regole e limiti: ecco le attività che non si fermano Autocertificazione anche per chi va a piedi
«Sanificazione con l’aereo», il messaggio-bufala allarma i castellani: pioggia di telefonate alla Pm
Il grido di allarme del settore turistico: «A rischio le nostre aziende e centinaia di posti di lavoro»
Covid 19: salgono a 22 le vittime Nell’Anconetano 29 contagi in più «Andiamo verso il raddoppio dei casi»
Torna alla home page